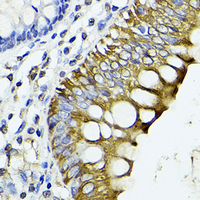

LGR5/GPR49 Rabbit Polyclonal Antibody
CAT.NO. : ARA6869
RMB Please choose
RMB Please choose
*产品价格可能会有所调整,请以品牌方官网实时更新的价格为准,以确保准确性。
Background
G protein-coupled receptor GPR49 has been reported to be expressed in brain, skeletal muscle, placenta, and spinal cord. ESTs have been isolated from normal human brain (amygdala), embryo, and placenta libraries and from human germ cell, uterus, and brain libraries. G-protein Coupled Receptors (GPCRs) comprise one of the largest families of signaling molecules with more than a thousand members currently predicted to exist. All GPCRs share a structural motif consisting of seven membrane-spanning helices, and exist in both active and inactive forms. An array of activating ligands participate in the conformation of GPCRs which leads to signaling via G-proteins and downstream effectors. Ongoing studies have also shown the vast series of reactions which participate in the negative regulation of GPCRs. This "turn-off" activity has tremendous implications for the physiological action of the cell, and continues to drive pharmacological research for new drug candidates.
Application
|
Application |
Dilution Ratio |
|
WB |
1:500 - 1:1000 |
|
IHC |
1:50 - 1:200 |
Overview
|
Immunogen |
Recombinant full length protein of human GPR49 |
|
Purification Method |
The antibody was purified by immunogen affinity chromatography. |
|
Clonality |
Polyclonal |
|
Product Form |
Liquid in 0.42% Potassium phosphate, 0.87% Sodium chloride, pH 7.3, 30% glycerol, and 0.01% sodium azide. |
|
Gene Name |
LGR5 |
|
Alternative Names |
GPR49; GPR67; Leucine-rich repeat-containing G-protein coupled receptor 5; G-protein coupled receptor 49; G-protein coupled receptor 67; G-protein coupled receptor HG38 |
|
Human Gene ID |
8549 |
|
Mouse Gene ID |
14160 |
|
Rat Gene ID |
299802 |
|
Human Protein ID |
O75473 |
|
Mouse Protein ID |
Q9Z1P4 |
|
Rat Protein ID |
D4AC13 |
Data

Western blot analysis of GPR49 expression in A431 (A), mouse brain (B), rat skeletal muscle (C) whole cell lysates. (Predicted band size: 92; 97; 99 kD; Observed band size: 100 kD)

Immunohistochemical analysis of GPR49 staining in human colon cancer formalin fixed paraffin embedded tissue section. The section was pre-treated using heat mediated antigen retrieval with sodium citrate buffer (pH 6.0). The section was then incubated with the antibody at room temperature and detected using an HRP conjugated compact polymer system. DAB was used as the chromogen. The section was then counterstained with haematoxylin and mounted with DPX.
Storage
Store at +4℃ after thawing. Aliquot store at -20℃. Avoid repeated freeze / thaw cycles.
Research Use Only
For Research Use Only. Not for use in diagnostic procedures.
 New Products
New Products